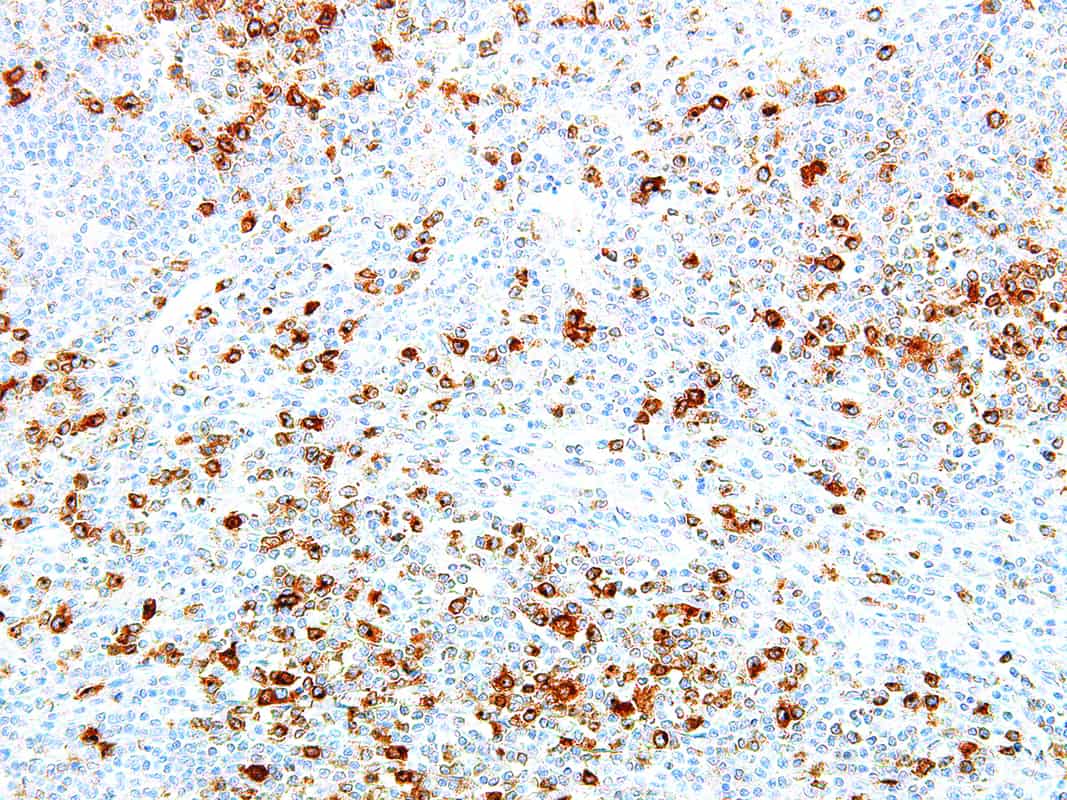
CD30

CD30
Cluster of differentiation 30 (CD30) is a transmembrane cytokine receptor expressed by activated T and B cells. It is present on Reed-Sternberg cells in Hodgkin’s lymphoma, most anaplastic large cell lymphomas, embryonal carcinomas, and primary cutaneous CD30 positive T-cell lymphoproliferative disorders. B-cell lymphomas are sometimes stained by Anti-CD30. Lymphomas exhibit Golgi zone accentuation when stained with Anti-CD30, while embryonal carcinomas produce membranous stains.
Specifications
| Clone | IHC030 |
| Source | Mouse Monoclonal |
| Positive Control | Classic Hodgkin Lymphoma, Lymphoma |
| Dilution Range | 1:50-1:200 |
Quantity
1.00
Select Volume
3 slides/package

Reviews
There are no reviews yet.